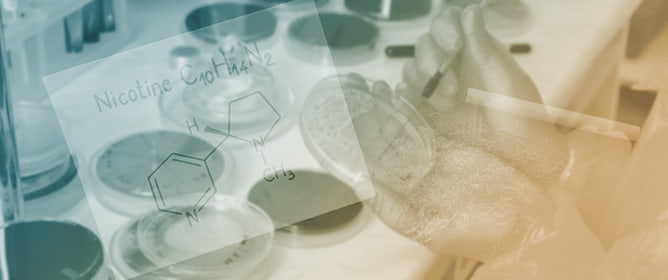
Effects of Nicotine on SH-SY5Y Cells: An NMR-Based Metabolomic Study

-
 Rumen Fluid Metabolomics and Microbiome Profiling of Dairy Cows Fed Combinations of Prebiotics, Essential Oil Blend, and Onion Peel Using the RUSITEC System
Rumen Fluid Metabolomics and Microbiome Profiling of Dairy Cows Fed Combinations of Prebiotics, Essential Oil Blend, and Onion Peel Using the RUSITEC System -
Effects of Nicotine on SH-SY5Y Cells: An NMR-Based Metabolomic Study
Effects of Nicotine on SH-SY5Y Cells: An NMR-Based Metabolomic Study -
 Maternal Inflammation During Pregnancy and Cord Blood Metabolomic Signatures in the Context of HIV Exposure
Maternal Inflammation During Pregnancy and Cord Blood Metabolomic Signatures in the Context of HIV Exposure -
 Evaluation of the Effect of Transcatheter Aortic Valve Implantation in Patients with Severe Aortic Stenosis on the Concentration of the Fatty Acids Involved in Inflammation
Evaluation of the Effect of Transcatheter Aortic Valve Implantation in Patients with Severe Aortic Stenosis on the Concentration of the Fatty Acids Involved in Inflammation
Journal Description
Metabolites
Metabolites
is an international, peer-reviewed, open access journal of metabolism and metabolomics, published monthly online by MDPI.
- Open Access— free for readers, with article processing charges (APC) paid by authors or their institutions.
- High Visibility: indexed within Scopus, SCIE (Web of Science), PubMed, PMC, Embase, CAPlus / SciFinder, and other databases.
- Journal Rank: JCR - Q2 (Biochemistry and Molecular Biology) / CiteScore - Q2 (Endocrinology, Diabetes and Metabolism)
- Rapid Publication: manuscripts are peer-reviewed and a first decision is provided to authors approximately 16.7 days after submission; acceptance to publication is undertaken in 3.6 days (median values for papers published in this journal in the second half of 2025).
- Recognition of Reviewers: reviewers who provide timely, thorough peer-review reports receive vouchers entitling them to a discount on the APC of their next publication in any MDPI journal, in appreciation of the work done.
Impact Factor:
3.7 (2024);
5-Year Impact Factor:
4.1 (2024)
Latest Articles
Shared Plasma Fatty Acid Profiles in Four Cancer Types Enable Diagnosis and Discrimination of Gastrointestinal and Lung Cancers
Metabolites 2026, 16(2), 128; https://doi.org/10.3390/metabo16020128 - 12 Feb 2026
Abstract
Background: Cancer is a leading cause of mortality worldwide, characterized by metabolic reprogramming, including alterations in fatty acid (FA) metabolism. Plasma FA profiles hold promise as non-invasive biomarkers for the diagnosis and classification of cancer. Objectives: This study aimed to investigate the diagnostic
[...] Read more.
Background: Cancer is a leading cause of mortality worldwide, characterized by metabolic reprogramming, including alterations in fatty acid (FA) metabolism. Plasma FA profiles hold promise as non-invasive biomarkers for the diagnosis and classification of cancer. Objectives: This study aimed to investigate the diagnostic potential of plasma FA profiles across four major cancers and to identify shared and cancer-type-specific metabolic alterations. Methods: We examine comprehensive FA profiling of plasma samples from 368 individuals, including patients with colorectal (CRC, n = 94), gastric (GC, n = 55), esophageal (EC, n = 53), and lung cancer (LC, n = 73), alongside 93 healthy controls (HCs) by gas chromatography–mass spectrometry. Data were analyzed using univariate statistics and multivariate modeling analysis. Results: Univariate analysis showed a shared set of altered FAs across the cancer types, demonstrating a shared pan-cancer metabolic shift. A comprehensive comparison revealed a remarkable shared pattern within the gastrointestinal (GI) cancers (GC, CRC, EC), while LC showed opposite trends for most FAs. Partial Least Squares Discriminant Analysis (PLS-DA) models on a 70% training set excellently discriminated each cancer type from HCs. The cross-validation of the model demonstrated robust internal performance with Q2 = 0.675 (LC), 0.559 (GC), 0.774 (CRC), and 0.628 (EC). This is followed by assessing the diagnostic accuracy on a 30% hold-out test set, with area under the curve (AUC) values of 0.686 (LC), 0.926 (GC), 0.905 (CRC), and 0.843 (EC). Conclusions: Plasma FA profiles may provide a potential source of biomarkers, capturing both shared cancer markers and distinct tissue-specific metabolic alterations. These findings highlight the high diagnostic and classificatory potential of FAs alterations in oncology.
Full article
(This article belongs to the Section Endocrinology and Clinical Metabolic Research)
►
Show Figures
Open AccessArticle
Genotype × Environment Shapes Fig Seed Oil Metabolic Fingerprinting
by
Charaf Ed-dine Kassimi, Souhaila Hadday, Souhaila Bouchelta, Ahmed Irchad, Ibtissame Guirrou, Karim Houmanat, Fedoua Diai, Lhoussain Hajji and Lahcen Hssaini
Metabolites 2026, 16(2), 127; https://doi.org/10.3390/metabo16020127 - 12 Feb 2026
Abstract
Background/Objectives: Fig (Ficus carica L.) seed oil represents an underexplored by-product with considerable nutraceutical potential. However, systematic evaluation of genotype × environment (G × E) interactions affecting its biochemical composition remains limited. This study assessed compositional variability across fig varieties, identified metabolic
[...] Read more.
Background/Objectives: Fig (Ficus carica L.) seed oil represents an underexplored by-product with considerable nutraceutical potential. However, systematic evaluation of genotype × environment (G × E) interactions affecting its biochemical composition remains limited. This study assessed compositional variability across fig varieties, identified metabolic trade-offs, and developed rapid authentication protocols using FTIR-ATR spectroscopy to support predictive G × E models and marker-assisted selection. Methods: Thirty-seven fig varieties were evaluated across two consecutive harvest years (2023–2024) in Morocco. Conventional biochemical analyses measured total phenolic content (TPC), total flavonoid content (TFC), DPPH and ABTS antioxidant activities, and oil yield. FTIR-ATR spectroscopy characterized spectral variations, with ANOVA assessing effects of year, variety, and G × E interactions. Principal Component Analysis (PCA) discriminated genotypes and years. Results: TPC varied substantially (16.5–115.1 mg GAE/100 g oil), declining 36% from 2023 (48.7 ± 16.6 mg GAE/100 g) to 2024 (31.2 ± 16.6 mg GAE/100 g; F = 1372.84, p < 0.001), with TFC showing parallel trends (15.6 vs. 11.8 mg QCE/100 g). DPPH activity increased 34% in 2024 (58.5% vs. 43.7%), while ABTS activity decreased 18.6% from 32.34 ± 14.28% to 26.31 ± 6.10% (p < 0.001). Oil yield decreased from 26.7% to 21.2% and negatively correlated with phenolic accumulation (r = −0.49, p < 0.001). FTIR-ATR identified diagnostic peaks (e.g., 3012, 2928 cm−1), with significant G × E effects (p < 0.001). PCA captured 75.4–84.5% variance, discriminating genotypes and years. Stable high-value cultivars included ‘Dottato Perguerolles’, ‘VCR 276/49’, and ‘Ferqouch Jmel’. Conclusions: Genotypic differences and year-to-year environmental conditions significantly influence fig seed oil composition. The observed negative correlation between oil yield and phenolic content indicates a trade-off between lipid biosynthesis and secondary metabolism. FTIR-ATR spectroscopy coupled with multivariate analysis enables reliable variety discrimination and year differentiation, supporting the development of stable cultivars for nutraceutical applications.
Full article
(This article belongs to the Special Issue The Influencing Factors of Nutrients and Metabolites in Plants)
►▼
Show Figures

Figure 1
Open AccessArticle
Sixty Years After a Coal Mine Disaster: Serum Metabolomic Profiles in Older Adults with Long-Term Sequelae of Carbon Monoxide Poisoning: A Cross-Sectional Study
by
Eriko Baba, Hiroo Matsuse, Ryuki Hashida, Norika Matsukuma, Yuji Maki, Masayuki Omoto, Yoshio Takano, Makiko Motooka and Hiromichi Motooka
Metabolites 2026, 16(2), 126; https://doi.org/10.3390/metabo16020126 - 12 Feb 2026
Abstract
Background: Survivors with chronic sequelae of carbon monoxide (CO) poisoning after the 1963 Miike–Mikawa coal mine disaster can exhibit persistent higher brain dysfunction in late life. We examined whether serum metabolic alterations remained detectable ~60 years later and assessed serum brain-derived neurotrophic factor
[...] Read more.
Background: Survivors with chronic sequelae of carbon monoxide (CO) poisoning after the 1963 Miike–Mikawa coal mine disaster can exhibit persistent higher brain dysfunction in late life. We examined whether serum metabolic alterations remained detectable ~60 years later and assessed serum brain-derived neurotrophic factor (BDNF). Methods: In this cross-sectional case–control study, outpatients with chronic CO-poisoning sequelae (CO; n = 14) and former miners without CO exposure (CON; n = 16), all aged ≥ 75 years, underwent targeted serum metabolomics (1183 metabolites) and clinical assessments. Between-group differences were evaluated using Welch’s t-test, and age-matched propensity-score matching (1:1) served as a sensitivity analysis. BDNF was additionally compared using a linear regression/ analysis of covariancemodel adjusting for age and Mini–Mental State Examination (MMSE). Results: Relative to controls, the CO group showed higher valine, alanine, and betaine and lower 3-hydroxybutyric acid, inosine, and hypoxanthine; these contrasts persisted with concordant direction after matching. Serum BDNF was lower in the CO group (unadjusted trend) and was significantly reduced after age/MMSE adjustment (p = 0.0252). Exploratory correlations between clinical measures and selected metabolites/BDNF were attenuated after accounting for group. Conclusions: Six decades after exposure, chronic CO sequelae were associated with a reproducible serum profile combining amino-acid elevations with relative suppression of ketone-body and purine-related metabolites, suggesting enduring alterations in systemic substrate handling and bioenergetics. If replicated in larger cohorts, such signatures—potentially alongside BDNF—should be regarded as hypothesis-generating; biomarker development would require external validation, longitudinal tracking, and assessment of intervention responsiveness before any clinical use is considered.
Full article
(This article belongs to the Special Issue Metabolomics Insights into Environmental Pollution: Unraveling Metabolic Responses to Contaminants)
►▼
Show Figures

Graphical abstract
Open AccessCorrection
Correction: Zhou et al. The Positive Regulatory Effect of DBT on Lipid Metabolism in Postpartum Dairy Cows. Metabolites 2025, 15, 58
by
Zheng Zhou, Kang Yong, Zhengzhong Luo, Zhenlong Du, Tao Zhou, Xiaoping Li, Xueping Yao, Liuhong Shen, Shumin Yu, Yixin Huang and Suizhong Cao
Metabolites 2026, 16(2), 125; https://doi.org/10.3390/metabo16020125 - 12 Feb 2026
Abstract
The authors would like to make the following correction to their published paper [...]
Full article
(This article belongs to the Section Animal Metabolism)
Open AccessArticle
The Impact of Nutritional Management on Fat-Soluble Nutrient Status in Patients with Fatty Acid Oxidation Disorders: A Cross-Sectional Study
by
Maria Wasiewicz-Gajdzis, Małgorzata Jamka, Łukasz Kałużny, Natalia Wichłacz-Trojanowska, Anna Blask-Osipa, Monika Duś-Żuchowska, Joanna Jagłowska, Szymon Kurek, Anna Miśkiewicz-Chotnicka and Jarosław Walkowiak
Metabolites 2026, 16(2), 124; https://doi.org/10.3390/metabo16020124 - 11 Feb 2026
Abstract
Background: Fatty acid oxidation disorders (FAOD) are rare inborn errors of metabolism that impair mitochondrial β-oxidation and energy production. Management includes fasting avoidance for all FAOD types. Patients with long-chain FAOD are advised to restrict long-chain triglycerides (LCTs) to 10% of total energy
[...] Read more.
Background: Fatty acid oxidation disorders (FAOD) are rare inborn errors of metabolism that impair mitochondrial β-oxidation and energy production. Management includes fasting avoidance for all FAOD types. Patients with long-chain FAOD are advised to restrict long-chain triglycerides (LCTs) to 10% of total energy intake and supplement medium-chain triglycerides (MCTs). The impact of such dietary modification on fat-soluble vitamin status has not yet been studied. Methods: In this cross-sectional study, serum concentrations of vitamins A, 25(OH)D, E, and β-carotene were measured in 36 FAOD patients and 36 healthy controls matched for age and sex. Vitamins A, E, and β-carotene were quantified using high-performance liquid chromatography and vitamin 25(OH)D through an immunoassay. FAOD patients were further divided into fat-modified (LCT-restricted) and standard-fat diet subgroups based on dietary management. Results: FAOD patients had significantly higher vitamin A concentrations than controls (p < 0.05), while there was no difference in vitamins 25(OH)D, E, and β-carotene. Within the FAOD cohort, the fat-modified group had higher levels of vitamins A and 25(OH)D but lower levels of vitamin E and β-carotene than the standard-fat group (all p < 0.05). Vitamin 25(OH)D deficiency (<20 ng/mL) was more frequent in the standard-fat group (p = 0.03). Conclusions: Fat-modified diets influence fat-soluble vitamin status in FAOD, emphasising the importance of ongoing monitoring and tailored supplementation. Future work should focus on optimising nutritional management, including modifications to formula composition, and on addressing the currently limited evidence on nutritional status and vitamin deficiencies in patients with FAOD.
Full article
(This article belongs to the Section Nutrition and Metabolism)
►▼
Show Figures

Figure 1
Open AccessCorrection
Correction: Hernández-Miranda et al. Impacts of Phenolic Compounds and Their Benefits on Human Health: Germination. Metabolites 2025, 15, 425
by
Jonathan Hernández-Miranda, Karen Argelia Reyes-Portillo, Abigail García-Castro, Esther Ramírez-Moreno and Alma Delia Román-Gutiérrez
Metabolites 2026, 16(2), 123; https://doi.org/10.3390/metabo16020123 - 11 Feb 2026
Abstract
The authors would like to make the following correction to their published paper [...]
Full article
(This article belongs to the Special Issue Plants and Plant-Based Foods for Metabolic Disease Prevention)
Open AccessArticle
Metabolic and Lactation Effects of Rumen-Protected Choline Supplementation in Peripartum Dairy Cows and Its Effects on Calf Growth Until Weaning
by
Ugur Serbester and Melisa Topaktas
Metabolites 2026, 16(2), 122; https://doi.org/10.3390/metabo16020122 - 10 Feb 2026
Abstract
Background: This study evaluated the effects of rumen-protected choline (RUPCHOL) supplementation in dairy cows from 21 days before calving to 28 days postpartum. The objective was to determine how RUPCHOL influences metabolic status, milk composition, and subsequent calf growth until weaning. Methods: Twenty-seven
[...] Read more.
Background: This study evaluated the effects of rumen-protected choline (RUPCHOL) supplementation in dairy cows from 21 days before calving to 28 days postpartum. The objective was to determine how RUPCHOL influences metabolic status, milk composition, and subsequent calf growth until weaning. Methods: Twenty-seven pregnant Holstein cows were assigned to a Control group (n = 13) or an RUPCHOL group (n = 14), both receiving a total mixed ration (TMR), with the RUPCHOL group supplemented with 15 g/day of choline chloride. Cows were monitored during prepartum, calving, and postpartum periods for body weight, body condition score, dry matter intake, rectal temperature, milk yield and composition, and blood metabolites. Results: RUPCHOL supplementation tended to reduce serum aspartate aminotransferase and lowered concentrations of non-esterified fatty acids and β-hydroxybutyrate, indicating improved metabolic status. Milk total solids, fat, and protein percentages were higher in RUPCHOL-fed cows, suggesting enhanced milk quality. Maternal supplementation did not affect colostrum immunoglobulin G (IgG) content or calf body weight and body measurements (heart girth, wither height, hip height, and body length) from birth to weaning. Conclusions: In summary, RUPCHOL supplementation improved indicators of metabolic health and milk composition of dairy cows during the peripartum period without altering calf growth outcomes.
Full article
(This article belongs to the Section Animal Metabolism)
►▼
Show Figures

Figure 1
Open AccessArticle
Carbohydrate and Fat Oxidation in Muscle Assessed with Exercise Calorimetry in 6465 Subjects
by
Jean-Frédéric Brun, Emmanuel Varlet, Justine Myzia, Emmanuelle Varlet-Marie, Eric Raynaud de Mauverger and Jacques Mercier
Metabolites 2026, 16(2), 121; https://doi.org/10.3390/metabo16020121 - 9 Feb 2026
Abstract
Background/Objectives: Exercise calorimetry provides a means to quantify the relative contributions of lipid and carbohydrate (CHO) oxidation across a range of exercise intensities. Although lipid oxidation capacity has been widely studied—particularly in relation to exercise prescription for individuals with obesity—the factors governing CHO
[...] Read more.
Background/Objectives: Exercise calorimetry provides a means to quantify the relative contributions of lipid and carbohydrate (CHO) oxidation across a range of exercise intensities. Although lipid oxidation capacity has been widely studied—particularly in relation to exercise prescription for individuals with obesity—the factors governing CHO oxidation during exercise are less clearly defined. This study therefore aimed to investigate, within a large single-center cohort, not only the established determinants of maximal lipid oxidation (LIPOXmax) but also those influencing CHO oxidation. Methods: Exercise calorimetry was performed in a cohort of 6465 individuals (4561 women and 1904 men; mean age 46.5 years; mean BMI 33.6 kg/m2). Two principal physiological indices were derived: LIPOXmax, defined as the exercise intensity eliciting maximal rates of fat oxidation, and the carbohydrate cost of the watt (CCW), defined as the slope characterizing the relationship between CHO oxidation and power output. Results: LIPOXmax showed positive associations with lean and muscle mass, and negative associations with fat mass and age, supporting the notion that greater muscle mass enhances the capacity for fat oxidation. Although men demonstrated higher absolute maximal fat oxidation rates, adjustment for body composition revealed that women exhibited relatively higher lipid oxidation (+30%, p < 0.001), occurring at a greater percentage of
(This article belongs to the Special Issue Interactions Between Exercise Physiology and Metabolism)
►▼
Show Figures

Graphical abstract
Open AccessReview
The Significance of the Heterogeneity of Cancer-Associated Fibroblasts in Tumor Microenvironments
by
Daiki Imanishi, Hinano Nishikubo, Dongheng Ma, Hongdong Gao, Tomoya Sano, Canfeng Fan, Takashi Sakuma, Yurie Yamamoto and Masakazu Yashiro
Metabolites 2026, 16(2), 120; https://doi.org/10.3390/metabo16020120 - 9 Feb 2026
Abstract
The tumor heterogeneity that is frequently observed in cancer tissues comprises not only cancer cells but also stromal cells in the tumor microenvironment. One of the major components of tumor stroma, i.e., cancer-associated fibroblasts (CAFs), play crucial roles in tumor progression and the
[...] Read more.
The tumor heterogeneity that is frequently observed in cancer tissues comprises not only cancer cells but also stromal cells in the tumor microenvironment. One of the major components of tumor stroma, i.e., cancer-associated fibroblasts (CAFs), play crucial roles in tumor progression and the tumor response to chemotherapy. The known subtypes of CAFs are antigen-presenting CAFs (apCAFs), myofibroblastic CAFs (myCAFs), and inflammatory CAFs (iCAFs). It has been speculated that (i) the heterogeneity of CAF subtypes might contribute to tumor progression; (ii) cell-to-cell interactions among CAF subtypes in tumors might be associated with the development of various types of carcinomas, and (iii) juxtracrine and/or paracrine signaling from CAFs may play important roles in this development. A clarification of the mechanisms that underlie the tumoral heterogeneity of CAFs could contribute to cancer treatment as precision medicine. This review explains the significance of CAF heterogeneity in tumor microenvironments, especially concerning the CAF subtypes.
Full article
(This article belongs to the Special Issue Mechanistic Insights into Metabolic Interactions with the Tumor Microenvironment)
►▼
Show Figures

Figure 1
Open AccessArticle
Transcriptomic Profiling Across Developmental Stages of Camellia petelotii (Merr.) Sealy Flower
by
Yi Wang, Xing Chen, Shihui Zou, Xuemei Li, Wei Guo and Lijiao Ai
Metabolites 2026, 16(2), 119; https://doi.org/10.3390/metabo16020119 - 9 Feb 2026
Abstract
Background: The Camellia genus is widely recognized for its remarkable diversity in floral morphology and coloration, with Camellia petelotii (Merr.) Sealy being particularly notable for its rare golden-yellow flowers, which possess exceptional ornamental value. Despite its horticultural significance, the molecular mechanisms governing
[...] Read more.
Background: The Camellia genus is widely recognized for its remarkable diversity in floral morphology and coloration, with Camellia petelotii (Merr.) Sealy being particularly notable for its rare golden-yellow flowers, which possess exceptional ornamental value. Despite its horticultural significance, the molecular mechanisms governing its flowering process remain poorly elucidated, presenting a substantial barrier to effective conservation and breeding initiatives. Methods: To address this knowledge gap, we conducted a comprehensive transcriptomic analysis, focusing on three distinct developmental stages of C. petelotii floral organs: the alabastrum stage (S1), the half-opened flower stage (S2), and the full bloom stage (S3). These samples were subjected to high-throughput sequencing using the Illumina platform. Following rigorous quality control and alignment with the reference genome, we performed transcript assembly and integrated comprehensive gene annotation data with quantitative gene expression profiles. Results: Our analysis identified 18,732 differentially expressed genes (DEGs) showing significant expression changes across developmental stages. Notably, we identified 134 DEGs as potential flowering-related genes, which were functionally associated with key pathways involved in floral regulation, including plant hormone signal transduction (e.g., AUX/IAA, ARF, SAUR, GH3, JAR4, GID1 and SOC1), starch (SS, SUS, BAM) and sucrose metabolism (HK, FrK, and GH32), circadian rhythm regulation (e.g., PIF3, ELF3, LHY, and PRR), and the Autonomous pathway. Building upon these findings, we have proposed a comprehensive model illustrating the regulatory network underlying flowering transition in C. petelotii. The reliability of the transcriptomic data was demonstrated through the validation of 11 genes using quantitative real-time PCR (qRT-PCR). Conclusions: These insights not only enhance our understanding of the molecular basis of flowering in this species but also provide a valuable theoretical framework for future genetic improvement and breeding programs of C. petelotii.
Full article
(This article belongs to the Special Issue Metabolomics and Plant Defence, 2nd Edition)
►▼
Show Figures

Figure 1
Open AccessArticle
Targeting Inflammation with Dietary ω-3 Polyunsaturated Fatty Acids Improved Lipid Mobilization and Flux in Heat-Stressed Wether Lambs
by
Shelley A. Curry, Melanie R. White, Micah S. Most, Pablo C. Grijalva, Rachel L. Gibbs, Eileen S. Marks-Nelson, Ty B. Schmidt and Dustin T. Yates
Metabolites 2026, 16(2), 118; https://doi.org/10.3390/metabo16020118 - 9 Feb 2026
Abstract
Background/Objectives: Chronic heat stress impairs lipid mobilization from adipocytes, which reduces substrate availability for muscle metabolism. Systemic inflammation is a key facilitative response to heat stress, and we sought to determine if mitigating inflammation in heat-stressed wether lambs would improve lipid flux. Methods:
[...] Read more.
Background/Objectives: Chronic heat stress impairs lipid mobilization from adipocytes, which reduces substrate availability for muscle metabolism. Systemic inflammation is a key facilitative response to heat stress, and we sought to determine if mitigating inflammation in heat-stressed wether lambs would improve lipid flux. Methods: Two cohorts of commercial feedlot lambs were heat stressed for 30 days. In study 1, heat-stressed lambs received dexamethasone injections every 3 days, fish oil capsules twice daily, or no intervention. In study 2, heat-stressed lambs received daily boluses of ω-3 polyunsaturated fatty acid Ca2+ salts (ω-3 PUFA) or no intervention. Results: In both studies, heat stress reduced ex vivo epinephrine-stimulated free fatty acid and glycerol mobilization from visceral adipose tissue. These deficits were partially resolved by fish oil and fully resolved by ω-3 PUFA. In study 1, fish oil recovered heat stress-induced deficits in circulating triglycerides and HDL-cholesterol but not in circulating free fatty acids. Fish oil and dexamethasone resolved the increase in muscle PPARα, indicating less lipid utilization for metabolism. In study 2, ω-3 PUFA resolved heat stress-induced deficits in muscle CD36 and PPARγ, indicating improved lipid uptake capacity. However, interventions did not resolve reduced intramuscular lipid content in either study. Conclusions: We conclude that inflammation was a primary facilitator of impaired lipid mobilization in heat-stressed lambs but was not the sole driver of lipid dysregulation. Nevertheless, targeting inflammation was a beneficial strategy for improving lipid flux during chronic heat stress.
Full article
(This article belongs to the Section Animal Metabolism)
►▼
Show Figures

Figure 1
Open AccessArticle
Partial Serotonin Transporter Deficiency Modulates Plasma Metabolome, Arginine-Nitric Oxide Pathway and Emotional Behavior in Mice Exposed to Western Diet
by
Anna Gorlova, Raymond Cespuglio, Angelika Schmitt-Böhrer, Alexey Deykin, Allan V. Kalueff, Ksenia Lebedeva, Andrey Nedorubov, Gabriela Ortega Shulte, Evgeniy Svirin, Aleksey Lyundup, Klaus-Peter Lesch and Tatyana Strekalova
Metabolites 2026, 16(2), 117; https://doi.org/10.3390/metabo16020117 - 9 Feb 2026
Abstract
Background/Objectives: Reduced serotonin transporter (SERT) function is associated with increased vulnerability to emotional and metabolic dysregulation, particularly in elderly women. Most preclinical studies relied on young male rodents with complete Sert deficiency; the Western diet (WD) acerbates these abnormalities. However, complete Sert
[...] Read more.
Background/Objectives: Reduced serotonin transporter (SERT) function is associated with increased vulnerability to emotional and metabolic dysregulation, particularly in elderly women. Most preclinical studies relied on young male rodents with complete Sert deficiency; the Western diet (WD) acerbates these abnormalities. However, complete Sert loss does not fully reflect the human condition of partial SERT dysfunction. Here, we examined the effects of WD in aged female Sert+/− mice on metabolic, biochemical, molecular, and behavioral outcomes. Methods: Wild-type (WT) and Sert+/− mice were fed WD or a control diet. Emotionality, cognition, glucose tolerance (GT), plasma 1HNMR spectroscopy metabolome and biochemical parameters were studied. Gene expression analyses of nitric oxide (NO)-related markers were performed in the hypothalamus, dorsal raphe, and liver. Results: WD-exposed WT mice showed impaired GT and reduced plasma lactate and branched-chain amino acid levels; metabolome changes were more pronounced in mutants, while GT was unchanged. Naïve Sert+/− mice exhibited lower lactate and alanine levels compared with WT controls. WD increased leptin and cholesterol levels in both genotypes, whereas triglyceride concentrations were reduced in Sert+/− mice. Both WD and Sert deficiency increased Nos expression, while arginase expression was differentially regulated by genotype and diet. Malondialdehyde levels were elevated in the prefrontal cortex of Sert+/− mice regardless diet. WD also impaired object recognition memory and induced anxiety- and depression-like behaviors, with more pronounced effects in Sert+/− mice, except marble test behavior. Conclusions: Partial Sert deficiency aggravates some but not all WD-induced metabolic alterations, enhances oxidative stress, dysregulates arginine–NO signaling, and modifies behavior, highlighting the translational relevance of Sert+/− mice for modeling SERT dysfunction.
Full article
(This article belongs to the Special Issue Metabolomics in Human Diseases and Health: 2nd Edition)
►▼
Show Figures

Figure 1
Open AccessArticle
Identifying Metabolite–Disease Associations via Messaging in Hypergraphs
by
Fuheng Xiao, Yihao Ran and Zhanchao Li
Metabolites 2026, 16(2), 116; https://doi.org/10.3390/metabo16020116 - 9 Feb 2026
Abstract
Background: Traditional machine-learning approaches face challenges when attempting to integrate diverse biological information for predicting metabolite–disease relationships. The intricate connections linking metabolites, diseases, proteins, and Gene Ontology (GO) annotations present substantial obstacles for conventional pairwise graph representations, which prove inadequate for modeling such
[...] Read more.
Background: Traditional machine-learning approaches face challenges when attempting to integrate diverse biological information for predicting metabolite–disease relationships. The intricate connections linking metabolites, diseases, proteins, and Gene Ontology (GO) annotations present substantial obstacles for conventional pairwise graph representations, which prove inadequate for modeling such complex multi-way interactions. Methods: An innovative hypergraph-based framework (DHG-LGB) was developed to exploit this complexity through conceptualizing diseases as hyperedges. Within this architecture, individual hyperedges link multiple vertices including metabolites, proteins, and GO annotations, thereby enabling richer representation of the biological networks underlying metabolite–disease relationships. Metabolite–disease relationships were encoded as low-dimensional vectors through hypergraph neural network (HGNN) operations incorporating Laplacian smoothing and message propagation mechanisms. LightGBM (LGB) was used to construct a model for identifying the potential metabolite–disease associations. Results: Under 5-fold cross-validation, DHG-LGB achieved 98.87% accuracy, 91.77% sensitivity, 99.58% specificity, 95.60% precision, Matthews correlation coefficient (MCC) of 0.9305, receiver operating characteristic area under curve (AUC) of 0.9983, and precision-recall area under curve (AUPRC) of 0.9860. The framework maintained strong performance when tested with varying positive-to-negative ratios (spanning 1:1 through 1:10), consistently achieving AUC values exceeding 0.9954 and AUPRC values above 0.9820, thereby confirming excellent robustness and generalization capability. Comparative evaluations against existing methodologies verified the superiority of DHG-LGB. Conclusions: The DHG-LGB framework delivers more comprehensive modeling of biological interactions relative to conventional approaches and substantially enhances predictive accuracy for metabolite–disease relationships. It is foreseeable that it will be a valuable computational tool for biomarker identification and precision medicine initiatives.
Full article
(This article belongs to the Section Endocrinology and Clinical Metabolic Research)
►▼
Show Figures

Figure 1
Open AccessArticle
Lipid-Lowering and Hepatoprotective Effects of Basil-Enriched Soybean Oil (BEO) in High-Fat-Diet-Fed Mice
by
Amani Tayebi, Mohammadine Moumou, Abdelhay Addous, Oussama Khibech, Niama Hammani, Youssra Salhi, Dragan Milenkovic, Ahmed Karim, Mohammed Choukri, Souliman Amrani and Hicham Harnafi
Metabolites 2026, 16(2), 115; https://doi.org/10.3390/metabo16020115 - 5 Feb 2026
Abstract
Background: This study investigated the hypolipidemic and hepatoprotective effects of refined soybean oil supplemented with an Ocimum basilicum L. extract, characterized by HPLC and found to be rich in caftaric, caffeic, chicoric, and rosmarinic acids. Methods: After a 12-week model of diet-induced hyperlipidemia,
[...] Read more.
Background: This study investigated the hypolipidemic and hepatoprotective effects of refined soybean oil supplemented with an Ocimum basilicum L. extract, characterized by HPLC and found to be rich in caftaric, caffeic, chicoric, and rosmarinic acids. Methods: After a 12-week model of diet-induced hyperlipidemia, we examined the plasma levels of TC, TG, Glucose, HDL-C, and LDL-C and the LDL-C/HDL-C ratio using enzymatic kits. The Plasma Hepatic and Biliary Marker Analysis was analysed following standardized hospital protocols with quality-controlled instrumentation. Results: The supplementation with Basil-Enriched Oil (BEO) resulted in a notable redistribution of lipids, significantly reducing the plasma total cholesterol (−75%), triglycerides (−96%), and glucose (−22%), while enhancing their hepatic sequestration. This was accompanied by a marked improvement in the LDL-C/HDL-C ratio and a reduction in hepatic oxidative stress (measured by MDA). Importantly, BEO preserved liver structure and prevented steatosis, despite inducing an increase in adaptive hepatomegaly. Conclusions: The results reveal a dual mechanism whereby the antioxidant properties of BEO collaborate with reprogrammed lipid metabolism, promoting safe hepatic storage rather than harmful circulating levels. These findings strongly advocate for the extract’s potential as a nutraceutical for addressing hyperlipidemia and related metabolic disorders by targeting both oxidative stress and lipid imbalance. Further research is required to confirm these effects in clinical settings and to confirm its long-term efficacy.
Full article
(This article belongs to the Special Issue Phytochemicals and Pharmacological Significance of Plant Secondary Metabolites in Medicine)
►▼
Show Figures

Figure 1
Open AccessArticle
The Metabolic Signatures Associated with the Effects of Aerobic Exercise on Depressive-like Behaviors in CUMS Rats
by
Huan Xiang, Danhui Zhang, Yuchen Zhu, Jiangtao Hou and Yumei Han
Metabolites 2026, 16(2), 114; https://doi.org/10.3390/metabo16020114 - 5 Feb 2026
Abstract
Objectives: This study explored the antidepressant mechanisms of aerobic exercise in CUMS rats by analyzing urinary metabolomics (LC-MS and NMR), with the aim of providing both theoretical and practical support for exercise-based depression interventions. Methods: (1) Thirty-two Sprague-Dawley rats were acclimatized
[...] Read more.
Objectives: This study explored the antidepressant mechanisms of aerobic exercise in CUMS rats by analyzing urinary metabolomics (LC-MS and NMR), with the aim of providing both theoretical and practical support for exercise-based depression interventions. Methods: (1) Thirty-two Sprague-Dawley rats were acclimatized for one week and then randomly assigned to four groups (n = 8 per group): control (C), control + aerobic exercise group (E), CUMS model (D), and CUMS + exercise (DE). Groups D and DE were subjected to nine types of CUMS stimuli. Behavioral indicators were assessed weekly, and the successful establishment of the CUMS model was confirmed at week 3. Following successful modeling, rats in groups E and DE underwent four weeks of aerobic exercise training. Throughout this period, groups D and DE continued to receive CUMS exposure, while groups C and E were maintained under standard control conditions. (2) At the end of week 7, behavioral tests were repeated. Twelve-hour urine samples were collected for metabolomic analysis using liquid chromatography–mass spectrometry (LC-MS) and 1H-NMR spectroscopy. The following morning, rats were euthanized under anesthesia. Whole blood was collected from the abdominal aorta, and serum was separated for subsequent biochemical assays. Bioinformatics approaches were employed to identify potential targets and signaling pathways associated with the antidepressant effects of aerobic exercise. (3) For statistical analysis, one-way or two-way analysis of variance (ANOVA) was applied to behavioral, physiological, and biochemical data, whereas multivariate statistical analysis was used for metabolomic data. Results: (1) By week 3, body mass, sucrose preference, rearing frequency, and the number of grid crossings were significantly lower in groups D and DE than in groups C and E (p < 0.05 or p < 0.01). These findings confirmed the successful establishment of the depression model. At week 7, all behavioral indicators in group DE showed significant recovery relative to group D (p < 0.05 or p < 0.01). (2) Compared with group C, corticosterone and blood ammonia levels were significantly elevated in group D (p < 0.01). In contrast, these levels were markedly reduced in group DE compared with group D (p < 0.01). (3) LC-MS analysis identified 25 urinary metabolites associated with depression in group D relative to group C. Among these, 21 were significantly downregulated and 4 were upregulated (p < 0.05 or p < 0.01), involving seven metabolic pathways. Following aerobic exercise intervention, six of these depression-related metabolites in group DE showed significant recovery (p < 0.05 or p < 0.01), which were associated with two metabolic pathways. (4) Integrated analysis of LC-MS and 1H-NMR data revealed glutamine as a common differential metabolite, linked to three metabolic pathways. All metabolic pathways modulated by aerobic exercise were related to amino acid metabolism. (5) Bioinformatics analysis indicated that AKT1, MTOR, IL6, RAF1, and TNF were core targets through which aerobic exercise regulated urinary metabolism in CUMS rats. Conclusions: A four-week regimen of aerobic exercise significantly improved depressive-like behaviors and enhanced anti-fatigue capacity in CUMS rats. This exercise regimen promoted urinary metabolic remodeling, primarily through the modulation of amino acid metabolism. Furthermore, its antidepressant effect is likely mediated through the regulation of core tissue targets—including AKT1, mTOR, IL-6, RAF1, and TNF—thereby influencing key pathways such as PI3K-AKT, MAPK/ERK, and neuroinflammatory signaling.
Full article
(This article belongs to the Special Issue Effects of Stress on Animal Metabolism)
►▼
Show Figures

Figure 1
Open AccessArticle
Investigation of Storage Conditions and Quality Control Markers for Metabolites and Lipids in Human Feces
by
Hiroshi Sawada, Motohiko Morihara, Masamitsu Gotou, Kazuyuki Fujii, Yuya Hidoh, Yasuhiro Sawai, Takashi Matsumoto, Taiki Nakaya, Osamu Miura, Tomohiro Ando, Kazutaka Ikeda and Jun Terauchi
Metabolites 2026, 16(2), 113; https://doi.org/10.3390/metabo16020113 - 4 Feb 2026
Abstract
Background/Objectives: The stability of metabolites and lipids in feces varies depending on the storage temperature and duration. Methods: We examined the stability of various metabolites and lipids in human feces under 10 different storage conditions (room temperature for 2, 6, 24,
[...] Read more.
Background/Objectives: The stability of metabolites and lipids in feces varies depending on the storage temperature and duration. Methods: We examined the stability of various metabolites and lipids in human feces under 10 different storage conditions (room temperature for 2, 6, 24, and 48 h, 4 °C for 6, 24, and 48 h, −20 °C for 1 week, 2 weeks and 1 month) and explored markers useful for quality control of fecal samples, using metabolites and lipids that vary depending on temperature and time. Results: There was generally more variation at 4 °C than at −20 °C, and more at room temperature than at 4 °C, and variation also increased as the storage duration was extended under each temperature condition. Some metabolites and lipids were found to be unstable, even over short periods (2 or 6 h) at room temperature or 4 °C storage. However, storage at −20 °C generally maintained the stability of most of them for up to two weeks. Our results suggest that the following ratios can serve as useful quality control markers: methionine to S-methyl-5-thioadenosine, xanthine to inosine and N-linoleoyl leucine to 1,2-dilinoleoyl-sn-glycerol. Conclusions: For comprehensive metabolite and lipid analysis, we recommend promptly transferring samples to −80 °C storage, except when stored at −20 °C for no longer than two weeks, with checks on markers for quality control. When measuring specific metabolites or lipids, our catalog data can be consulted to determine acceptable storage conditions.
Full article
(This article belongs to the Section Endocrinology and Clinical Metabolic Research)
►▼
Show Figures

Figure 1
Open AccessArticle
Evidence for a Cytokine-Sensitive Network of Iron-Associated Genes That Protects Pancreatic Islets Against Ferroptosis
by
Kira G. Slepchenko, Grace P. Counts, Poonam R. Sharma, Si Chen, Kathryn L. Corbin, Farhan M. Qureshi, Robert A. Colvin, C. Martin Lawrence and Craig S. Nunemaker
Metabolites 2026, 16(2), 112; https://doi.org/10.3390/metabo16020112 - 4 Feb 2026
Abstract
Background/Objectives: The micronutrient iron is closely connected to inflammation and is among the complex factors contributing to beta-cell failure in diabetes. High levels of dietary iron increase the risk of developing type 2 diabetes, and excessive iron uptake by beta-cells can cause
[...] Read more.
Background/Objectives: The micronutrient iron is closely connected to inflammation and is among the complex factors contributing to beta-cell failure in diabetes. High levels of dietary iron increase the risk of developing type 2 diabetes, and excessive iron uptake by beta-cells can cause oxidative stress and inhibit function. Elevated levels of proinflammatory cytokines in obese individuals, such as interleukin (IL)-1beta and IL-6, increase the risk of developing type 2 diabetes, and there is evidence that these low levels of circulating cytokines can lead to islet dysfunction. Methods: In this study, gene microarray and other data were analyzed for expression differences in islets treated for 48 h with 10 pg/mL IL-1beta + 20 pg/mL IL-6 as a model of low-grade inflammation versus untreated. Results: Three iron-associated genes were among the most cytokine-sensitive in the mouse genome: Hamp, Steap4, and Lcn2. These proteins are all involved with increasing/retaining cellular iron. We hypothesized that increased cellular iron would lead to increased susceptibility to ferroptosis. Surprisingly, 24 h pre-exposure to low-grade inflammation, which upregulates this iron-gene network, prevented subsequent erastin-induced ferroptosis. We also found that Steap4 overexpression reduced islet dysfunction caused by high-dose proinflammatory cytokines (10× low-dose), suggesting an overall protective effect. Steap4 overexpression also upregulated Hamp and Lcn2, suggesting Steap4 regulates these cytokine-sensitive iron genes.; in contrast, ferritin and ferroportin gene expression, which are not sensitive to cytokines, were unchanged. Conclusions: These data suggest an inflammation-induced network of genes involved in cellular iron uptake and retention plays a protective role in islets against oxidative stress and ferroptosis.
Full article
(This article belongs to the Special Issue Role of Metabolic Factors and Their Interactions on Diabetes and Its Complications)
►▼
Show Figures

Graphical abstract
Open AccessArticle
Circulating CCDC3 as an Indicator of Visceral Fat Accumulation in Patients with Type 2 Diabetes Mellitus
by
Lin Zhu, Xiaodie Fan, Jiangang Lu, Yutao He, Youyuan Gao, Sirong He, Longbin Lai, Ruobei Zhao, Rui Cheng, Xi Li, Fengning Chuan and Bin Wang
Metabolites 2026, 16(2), 111; https://doi.org/10.3390/metabo16020111 - 3 Feb 2026
Abstract
Background: Visceral fat plays a central role in cardiometabolic risk among people with type 2 diabetes mellitus (T2DM), yet its assessment in routine clinical practice remains largely dependent on imaging techniques or indirect anthropometric measures. Identifying accessible blood-based markers that reflect visceral
[...] Read more.
Background: Visceral fat plays a central role in cardiometabolic risk among people with type 2 diabetes mellitus (T2DM), yet its assessment in routine clinical practice remains largely dependent on imaging techniques or indirect anthropometric measures. Identifying accessible blood-based markers that reflect visceral adiposity may facilitate improved phenotyping in this population. This study aimed to investigate whether circulating coiled-coil domain–containing protein 3 (CCDC3) reflects visceral fat accumulation in adults with T2DM. Methods: Public RNA-sequencing datasets and human adipose tissue samples were analyzed to identify CCDC3 as a visceral fat–enriched secretory gene. In this cross-sectional study of 160 adults with T2DM undergoing dual-energy X-ray absorptiometry, plasma CCDC3 was measured by ELISA. Associations between plasma CCDC3 and visceral fat area (VFA) were examined using multivariable regression. Logistic regression models for abdominal obesity (VFA ≥ 100 cm2), with and without CCDC3, were evaluated using receiver operating characteristic (ROC) analysis, calibration curves, decision curve analysis (DCA), and Shapley additive explanations (SHAP). Results: Circulating CCDC3 levels were positively associated with VFA (β = 3.11, p < 0.001), independent of demographic and metabolic factors. Incorporating CCDC3 into the baseline model significantly improved discrimination of abdominal obesity (AUC 0.820 vs. 0.663; p = 0.009). Calibration curves and DCA supported better model fit and higher net clinical benefit with CCDC3. SHAP analysis showed that CCDC3 contributed the greatest incremental importance beyond waist circumference, sex, and age. Conclusions: Circulating CCDC3 may serve as a blood-based biomarker reflecting visceral adiposity in adults with T2DM and provides complementary information beyond traditional anthropometric measures.
Full article
(This article belongs to the Section Endocrinology and Clinical Metabolic Research)
►▼
Show Figures

Figure 1
Open AccessArticle
Triglyceride-to-HDL Cholesterol Ratio Is Associated with Ischemic Stroke Risk in Patients—With Paroxysmal Atrial Fibrillation
by
Ciprian Ilie Rosca, Daniel Florin Lighezan, Doina Georgescu, Horia Silviu Branea, Nilima Rajpal Kundnani, Ariana Violeta Nicoras, Romina Georgiana Bita and Daniel Dumitru Nisulescu
Metabolites 2026, 16(2), 110; https://doi.org/10.3390/metabo16020110 - 3 Feb 2026
Abstract
Background: Ischemic stroke remains the most feared complication of atrial fibrillation (AF), and thromboembolic risk is commonly estimated using clinical scores that may not fully capture the cardiometabolic dimension of cerebrovascular vulnerability. The aim of this research was to assess whether additional parameters
[...] Read more.
Background: Ischemic stroke remains the most feared complication of atrial fibrillation (AF), and thromboembolic risk is commonly estimated using clinical scores that may not fully capture the cardiometabolic dimension of cerebrovascular vulnerability. The aim of this research was to assess whether additional parameters can be used, to predict ischemic stroke risk in patients with AF, in order to explore whether TG/HDL-C may complement conventional clinical risk scores for ischemic stroke risk stratification in PAF, and to better characterize a metabolically high-risk phenotype beyond the recommendations provided by the CHA2DS2-VA score, which is useful but still far from perfect in predicting AF-associated ischemic stroke risk. Methods: In this retrospective, single-center observational study, we evaluated whether the triglyceride-to-high-density lipoprotein cholesterol ratio (TG/HDLc), a simple surrogate of atherogenic dyslipidemia and insulin resistance, is associated with ischemic stroke risk in patients with paroxysmal atrial fibrillation (PAF). We screened 1111 consecutive AF admissions between 1 January 2015 and 31 December 2016 and, from these 1111 AF cases, we extracted only the patients with PAF for analysis. Patients were stratified based on TG/HDLc values into two groups, Group 1 (TG/HDLc > 2.5; n = 155) and Group 2 (TG/HDLc < 2.5; n = 194). Statistical analysis was performed with MedCalc v23.4.0 using Chi-square and unpaired/Welch’s t-tests as appropriate, Pearson correlations, Kaplan–Meier analysis with log-rank testing, Cox regression for first ischemic stroke, and multivariable logistic regression to identify independent correlates of TG/HDLc > 2.5. Results: Patients with TG/HDLc > 2.5 had a significantly higher prevalence of ischemic stroke after AF onset compared with those with TG/HDLc < 2.5 (37.4% vs. 21.1%, p = 0.0008), despite similar CHA2DS2-VA and HAS-BLED scores, and also exhibited a higher burden of cerebrovascular and neurodegenerative findings, including cortical atrophy and cerebral lacunarism. Ischemic stroke-free survival curves diverged significantly over time (log-rank p = 0.0186), and an elevated TG/HDLc ratio was associated with a 68% higher hazard of first ischemic stroke (HR 1.68; 95% CI 1.09–2.60). In multivariable analysis, type 2 diabetes mellitus (OR 4.53), hyperuricemia (OR 3.83), dyslipidemia (OR 1.94), stroke (OR 1.77), and cortical atrophy (OR 4.48) were independently associated with TG/HDLc > 2.5. Conclusions: These findings suggest that TG/HDLc identifies a metabolically high-risk PAF phenotype associated with greater cerebrovascular burden and reduced ischemic stroke-free survival, providing an inexpensive and broadly available marker that may complement conventional clinical risk scores.
Full article
(This article belongs to the Special Issue Current Research in Metabolic Syndrome and Cardiometabolic Disorders)
►▼
Show Figures

Graphical abstract
Open AccessArticle
Integrative LC-HR-QTOF-MS and Computational Metabolomics Approaches for Compound Annotation, Chemometric Profiling and In Silico Antibacterial Evaluation of Ugandan Propolis
by
Ivan Kahwa, Christina Seel, Ronnie Tumwesigye, Patrick Onen, Ramona Oehme, Susan Billig, Rapheal Wangalwa, Jonans Tusiimire, Claudia Wiesner and Leonard Kaysser
Metabolites 2026, 16(2), 109; https://doi.org/10.3390/metabo16020109 - 3 Feb 2026
Abstract
Background/Objectives: Propolis is a complex bee product with a composition that varies according to local vegetation, environmental conditions, and bee foraging behaviours. Recently, gas chromatography–mass spectrometry (GC–MS) has been employed in Uganda to analyse its volatile components. This study examined Ugandan propolis
[...] Read more.
Background/Objectives: Propolis is a complex bee product with a composition that varies according to local vegetation, environmental conditions, and bee foraging behaviours. Recently, gas chromatography–mass spectrometry (GC–MS) has been employed in Uganda to analyse its volatile components. This study examined Ugandan propolis non-volatile metabolites to determine chemotypes and identify antibacterial compounds. Methods: Ethanolic extracts were analysed using liquid chromatography–high-resolution quadrupole time-of-flight mass spectrometry (LC-HR-QTOF-MS) in an untargeted MS/MS mode. Data processing was carried out using MZmine, then annotated with Global Natural Products Social Molecular Networking (GNPS) and SIRIUS. Chemometric methods assisted in identifying regional chemical signatures. Metabolites highlighted by the heatmap were evaluated for antibacterial activity using molecular docking against bacterial targets, followed by ADMET (absorption, distribution, metabolism, excretion, and toxicity) assessments. Results: Out of 3252 features, 234 and 52 putative compounds were annotated in GNPS and SIRIUS, respectively, as indicated by molecular networking, suggesting high chemical complexity. The chemical space mainly comprises flavonoids (including glycosides, aglycones, methylated, and prenylated derivatives), phenolic acids, amides, hydroxycinnamate derivatives, lignans, megastigmanes, and various diterpenoid skeletons. Multivariate analyses clearly distinguish geographical chemotypes, separating flavonoid-rich regions from diterpenoid-rich regions. Docking studies revealed flavonoids, diterpenoids, and lignans with strong predicted antibacterial activities and favourable ADMET profiles. Conclusions: This study provides the first LC–MS characterisation of the non-volatile metabolome of Ugandan propolis, thereby expanding its chemical diversity. Metabolomics and computational approaches lay a foundation for future ecological, chemotaxonomic, and pharmacological research.
Full article
(This article belongs to the Special Issue Advances on Metabolomics: Driving Innovation in Bio-Analysis and Natural Products Research)
►▼
Show Figures

Figure 1

Journal Menu
► ▼ Journal Menu-
- Metabolites Home
- Aims & Scope
- Editorial Board
- Reviewer Board
- Topical Advisory Panel
- Instructions for Authors
- Special Issues
- Topics
- Sections & Collections
- Article Processing Charge
- Indexing & Archiving
- Editor’s Choice Articles
- Most Cited & Viewed
- Journal Statistics
- Journal History
- Journal Awards
- Conferences
- Editorial Office
Journal Browser
► ▼ Journal BrowserHighly Accessed Articles
Latest Books
E-Mail Alert
News
Topics
Topic in
Applied Microbiology, Metabolites, Nutrients, Microorganisms
Microbiome Changes in Perimenopause: New Marker and Therapy Targets
Topic Editors: Dimitri Barski, Patrick FinzerDeadline: 31 March 2026
Topic in
Foods, Molecules, Nutrients, Metabolites
Omics Technologies and Other Quality and Safety Methodologies in Nutrition and Health
Topic Editors: Xianjiang Li, Wen MaDeadline: 1 June 2026
Topic in
Biomedicines, Cancers, Diagnostics, JCM, Metabolites, Targets
Biomarkers of Disease: Discovery and Clinical Applications
Topic Editors: Ioannis Kanakis, Andreas TsakalofDeadline: 30 June 2026
Topic in
Dairy, Foods, Microorganisms, Nutrients, Metabolites
The Efficacy of Probiotics and Their Functional Metabolites in Fermented Foods
Topic Editors: Rina Wu, Wenjun Liu, Zhen Wu, Feiyu AnDeadline: 31 July 2026

Conferences
Special Issues
Special Issue in
Metabolites
NMR-Based Metabolomics in Biomedicine and Food Science
Guest Editors: Gaia Meoni, Alessia VignoliDeadline: 13 February 2026
Special Issue in
Metabolites
Metabolism in Kidney Disease
Guest Editors: Vincenzo Calabrese, Elisa Longhitano, Domenico SantoroDeadline: 15 February 2026
Special Issue in
Metabolites
Effects of Nutrition and Exercise on Cardiometabolic Health
Guest Editor: Sam EmersonDeadline: 16 February 2026
Special Issue in
Metabolites
Metabolomic Insights: Interplay Between Metabolism and Immune Response in Cancer
Guest Editor: Dimitra Rafailia BakaloudiDeadline: 20 February 2026
Topical Collections
Topical Collection in
Metabolites
Feature Papers Related to Metabolomic Profiling Technology
Collection Editor: Thusitha Rupasinghe
Topical Collection in
Metabolites
Feature Papers in Assessing Environmental Health and Function
Collection Editor: David J. Beale
Topical Collection in
Metabolites
Advances in Metabolomics
Collection Editors: Leonardo Tenori, Edoardo Saccenti









